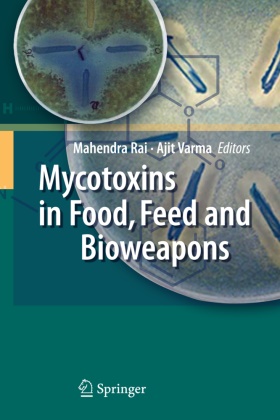

Read more
Mycotoxins are made by different biosynthetic pathways, and they have an extremely wide range of pharmacological effects. This book will update readers on several cutting-edge aspects of mycotoxin research, including topics such as: new analytical methods for detection; the adoption of an ancient Mexican process for detoxification of aflatoxins; mycotoxin management in Ireland, Lithuania and South America; mycotoxin reduction through plant breeding and integrated management practices; and natural aflatoxin inhibitors from medicinal plants. Further contributions examine ochratoxins, selected trichothecenes, zearalenone, and aflatoxin-like gene clusters, as well as sclerotial development in Aspergillus flavus and A. parasiticus. Of particular interest are the chapters on the potential use of mycotoxins as bioweapons. This book will stimulate new thinking on the need to develop therapeutic as well as preventative interventions to reduce the toxicological threat of mycotoxins.
List of contents
Biology and Biotechnology.- Artificial Systems for Molecular Recognition of Mycotoxins.- Molecular Mechanism of Detection of Aflatoxins and Other Mycotoxins.- The Destruction of Aflatoxins in Corn by "Nixtamalización".- Mycotoxigenic Fungi on Baled Grass Silage in Ireland.- Aflatoxin-like Gene Clusters and How They Evolved.- Aflatoxin Biosynthesis and Sclerotial Development in Aspergillus flavus and Aspergillus parasiticus.- Interaction Between Aflatoxin B1 and Other Risk Factors in Hepatocarcinogenesis.- Zearalenone and its Derivatives: Known Toxins in New Aspects.- Zearalenone: Undesirable Substance.- Agriculture and Food.- Mycotoxins in Lithuanian Cereals and Grain Products.- Control of Mycotoxin Contamination in Cereals by Breeding.- Fusarium and Fumonisins in Maize in South America.- Prevention and Management of Mycotoxins in Food and Feed.- Mycotoxigenic Fungi and Mycotoxins in Animal Feed in South American Countries.- Toxicology and Bioweapons.- Nivalenol: The Mycology, Occurrence, Toxicology, Analysis and Regulation.- Yeast Killer Toxins Technology Transfer.- Trichothecenes as Toxin and Bioweapons: Prevention and Control.- Risk Assessment of Ochratoxin A (OTA).- Natural Aflatoxin Inhibitors from Medicinal Plants.- The Myco-Agents of Bioterrorism.- The Weaponisation of Mycotoxins.- Masked Mycotoxins and Mycotoxin Derivatives in Food: The Hidden Menace.
Summary
Mycotoxins are made by different biosynthetic pathways, and they have an extremely wide range of pharmacological effects. This book will update readers on several cutting-edge aspects of mycotoxin research, including topics such as: new analytical methods for detection; the adoption of an ancient Mexican process for detoxification of aflatoxins; mycotoxin management in Ireland, Lithuania and South America; mycotoxin reduction through plant breeding and integrated management practices; and natural aflatoxin inhibitors from medicinal plants. Further contributions examine ochratoxins, selected trichothecenes, zearalenone, and aflatoxin-like gene clusters, as well as sclerotial development in Aspergillus flavus and A. parasiticus. Of particular interest are the chapters on the potential use of mycotoxins as bioweapons. This book will stimulate new thinking on the need to develop therapeutic as well as preventative interventions to reduce the toxicological threat of mycotoxins.
Additional text
From the reviews:
“The book is organized into three general areas. They are: Biology and biotechnology, Agriculture and food, and Toxicology and bioweapons. … Information is presented in sufficient depth to engage readers with an interest in mycotoxins or mycology. Researchers looking for a compendium of recent and relevant information on mycotoxins should consider adding this book to their reference shelf.” (H. Schurz Rogers, World Mycotoxin Journal, Vol. 3 (2), May, 2010)
“Mycotoxins have been reviewed many times, but this book claims to target new areas, including new detection methods, an ancient Mexican process for detoxification, mycotoxin management … . printed on good quality paper, has four colour features, 405 pages, 35 illustrations and the text is of average size. … chapters are very varied, with a range of interesting topics, and provide a very good account of the topic of mycotoxins by an expert group of authors. The book should be available in University libraries.” (Fungal Diversity, Vol. 49 (1), July, 2011)
Report
From the reviews:
"The book is organized into three general areas. They are: Biology and biotechnology, Agriculture and food, and Toxicology and bioweapons. ... Information is presented in sufficient depth to engage readers with an interest in mycotoxins or mycology. Researchers looking for a compendium of recent and relevant information on mycotoxins should consider adding this book to their reference shelf." (H. Schurz Rogers, World Mycotoxin Journal, Vol. 3 (2), May, 2010)
"Mycotoxins have been reviewed many times, but this book claims to target new areas, including new detection methods, an ancient Mexican process for detoxification, mycotoxin management ... . printed on good quality paper, has four colour features, 405 pages, 35 illustrations and the text is of average size. ... chapters are very varied, with a range of interesting topics, and provide a very good account of the topic of mycotoxins by an expert group of authors. The book should be available in University libraries." (Fungal Diversity, Vol. 49 (1), July, 2011)